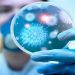
تونس تغلق حدودها البحرية في وجه الملاحة البحرية.

أعلنت غرفة الصيد البحري الأطلسية الشمالية عن اتخاذ حزمة إجراءات مواكبة لجهود الحكومة للحد من تداعيات حائجة فيروس كوفيد19-كورنا،خاصة ما يهم ضمان تموين الأسواق بالمنتوجات البحرية الطرية.
و دعت غرفة الصيد البحري الأطلسية الشمالية في بلاغين لها عموم مهني الصيد البحري و تجارة السمك بميناء الدارالبيضاء و الصويرة و اسفي الى الالتزام الصارم بالقرارات و الإجراءات الرامية إلى الوقاية من فيروس كورونا، كما وجهت عنايتهم إلى الحرص على تطهير و تنظيف و تعقيم جميع بواخر الصيد و آليات الصيد عند كل رحلة بحرية مع مراقبة درجة حرارة أطقم وحدات الصيد، وكذا تزويد البواخر بمواد التنظيف و الوقاية و مقياس الحرارة.
و بخصوص تداول المنتوجات البحرية عند التفريغ ، قررت غرفة الصيد البحري الأطلسية الشمالية بتشاور مع مهني الصيد البحري و تجارة السمك اطلاق عمليات البيع بسوق السمك ابتداء من السابعة مساء بميناء الدارالبيضاء ، على أن لا يتجاوز عدد البواخر 10 وحدات تفاديا للازدحام، و الزام تجار السمك باستعمال وسائل الوقاية من كمامات و قفازات و ما شابه.
نفس الإجراءات الوقائية سيخضع لها ميناآ الصويرة و آسفي باستثناء التداول عبر أسواق البيع الأول حيث سيتم شحن المنتوجات البحرية مباشرة من المراكب نحو الشاحنات، لتقليص الاحتكاك و الحد من التداول ، هذا بعد إخضاع المفرغات للمراقبة و التصريح على الرصيف.
كما تقرر ابتداء من 19 مارس2020، تحديد عمليات البيع بالنسبة للصيد التقليدي زال كل يوم بميناء الصويرة، و في الخامسة بعد الزوال بالنسبة لمراكب الصيد بالجر بذات الميناء ، فيما أكدت غرفة الصيد البحري الأطلسية الشمالية استمرار مواعيد التداول و التثمين بميناء اسفي دون تغيير.